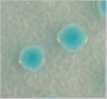

產品介紹
CHROMagar 科瑪嘉 酵素基質呈色培養基
獸醫專用培養基
科瑪嘉 Salmonella Plus / 科瑪嘉 沙門氏桿菌培養基 Plus
 |
產品說明:
科瑪嘉 CHROMagar Salmonella Plus
科瑪嘉 沙門氏桿菌培養基 Plus
產品編號:SA162
用於檢測及分離沙門氏桿菌(Salmonella species),包含乳糖發酵型沙門氏桿菌(lactose positive Salmonella)。
ISO 6579-1要求食品須檢測之微生物包含乳糖發酵型沙門氏桿菌。
微生物典型生長外觀:
沙門氏菌(含S. typhi, S. paratyphi A and lactose positive Salmonella) → 紫紅色
大腸桿菌 → 無色
大腸桿菌群 → 藍色
變形桿菌 → 無色或被抑制 |
| 產品名稱 : 科瑪嘉 Salmonella Plus / 科瑪嘉 沙門氏桿菌培養基 Plus |
| ► |
產品外觀 |
|
| |
 |
Salmonella spp including S. typhi & S. paratyphi → 紫紅色 |
| |
 |
E. coli → 無色 |
| |
|
Coliforms → 藍色 |
| ► |
培養基特性 |
| |
1. |
符合ISO 6579-1要求: |
| |
|
可檢測乳糖發酵型沙門氏桿菌。 |
| |
2 |
易於肉眼辨識: |
| |
|
沙門氏菌檢測樣本中常伴有大量的大腸桿菌,並有遮蓋沙門氏疑似菌落的可能性。而CHROMagar™ Salmonella Plus上的大腸桿菌為無色菌落、沙門氏菌為紫紅色菌落,兩者呈現明顯對比。 |
| |
3. |
沙門氏菌 (含S. typhi, S. paratyphi A and lactose positive Salmonella) → 高達99%*
* 科學研究之專一性與靈敏度:Beaumont C., Breuil J., Dedicova D.與Tran Q. 於2006年ECCMID會議所展示海報 – 評估新型科瑪家呈色培養基CHROMagar Salmonella Plus,其用於檢測沙門氏菌,包含S. typhi, S. paratyphi A及lactose positive Salmonella。 |
| ► |
培養基描述 |
| |
Powder Base |
Total ............................................................................... 32.8 g/L
Agar ................................................................................. 15.0
Peptone and Yeast extract .............................................. 8.0
Salts ................................................................................... 8.5
Chromogenic mix ............................................................. 1.3
Storage at 15/30 °C - pH: 7.5 ± 0.2
Shelf Life ........................................................................ 3 years |
| |
Supplement
(included in the pack) |
1st : Liquid form ............................................................. 6 mL/L
Storage at 15/30 °C Shelf Life ........... 5 years |
| |
CHROMagarTM White
Opaque supplement |
In order to obtain a white opaque background:
Powder form : ................................................................. 1.0 g/L
Storage at 15/30 °C Shelf Life ........... 3 years |
| |
Usual Samples |
food, meat, fresh eggs,milk products etc. |
| |
Procedure |
Inoculation after selective broth enrichment of samples
according to ISO 6579.
Incubation 18-24 h at 37 °C.
Aerobic conditions. |
| |
Scientific Publications on this product: available on www.CHROMagar.com
Please read carefully the instructions for use (IFU document) available on www.
CHROMagar.com |
| |
|
|
| |
Gain flexibility using powder rather than ready to use plates: Use the entire pack, or if there is a need for a smaller number of plates, just a portion. If kept under appropriate storage temperature, CHROMagarTM Salmonella Plus has a 3 years shelf life. This flexibility is essential to avoid the waste resulting from expired-unused plates.
-Meets ISO 6579-1 requirements : Microbiology of food and animal feeding stuffs. Horizontal method for the detection of Salmonella spp. It is applicable to products intended for human consumption and the feeding of animals, and to environmental samples in the area of food production and food handling.
Please refer to our IFU and Material Safety data sheet for complete information about the medium.
CHROMagar™, Rambach™, AquaCHROM™ are trademarks created by Dr. A. Rambach.
All pictures of our products are CHROMagar™ property and should not be used without our acceptance.
Last Update: 14-Dec-2018
|
| ► |
專為沙門氏菌檢驗所設計 |
| |
沙門氏菌為一種食源性病原體;而由沙門氏菌(含Salmonella typhi) 所引起的感染,仍是危害全球健康的主要問題之一: |
| |
• |
美國CDC於2008年預估沙門氏菌在該國的發生率為每100,000人16.2例。 |
| |
• |
根據歐洲食品安全局(EFSA)於2007年發表的報告:
沙門氏菌為歐洲集體毒素感染的首要原因。發展中國家的沙門氏菌感染通常為Salmonella typhi及 paratyphi,其年病例數達1700萬例
|
| |
|
|
| ► |
沙門氏菌症的流行病學議題 |
| |
沙門氏菌通常存在於肉類、蛋類及乳製品中,另也存在於水中,其中血清型S. typhi與S. paratyphi會導致傷寒及副傷寒(typhoid and paratyphoid fever)。
沙門氏菌可說在食品供應鏈中最為常見的檢驗及監測分析項目,因此,提高沙門氏菌的檢測效率除了能夠減少受沙門氏菌汙染的市售食品數量,也能有效節省微生物品質管控相關的經濟成本。 |
 |
| 有興趣請點選 |
 |
參觀選購 |
|
|

